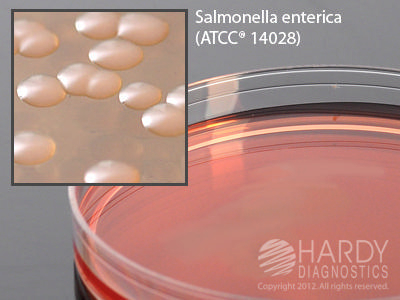

MACCONKEY AGAR , Pack of 10
$ 16.78
|
|
Details:
Medium^ Medium, MacConkey Agar, for the culture and isolation of Gram negative bacteria, controls swarming of Proteus, RSR, 15x100mm plate, reduced stacking ring for automated inoculating devices
Additional Information
| SKU | 23787624 |
|---|---|
| UOM | Pack of 10 |
| UNSPSC | 41106200 |
| Manufacturer Part Number | GA35 |
| Product Dimensions | 15X6X7 Inches |
| Product Weight | 0.8 |
